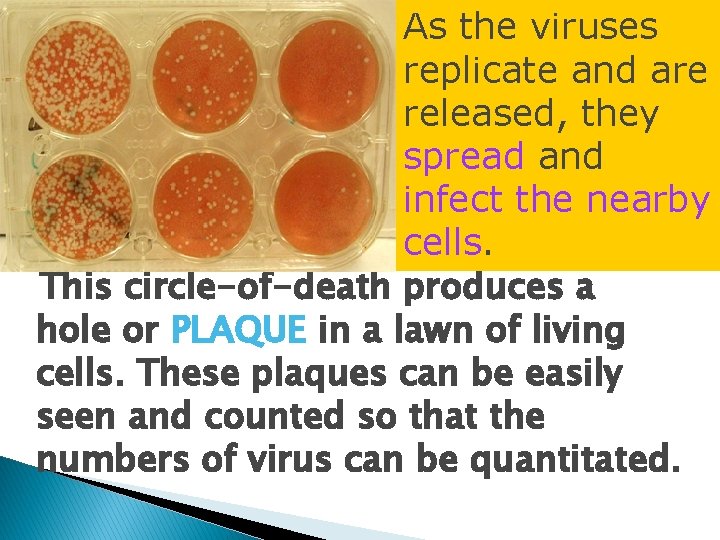
As the viruses replicate and are released, they spread and infect the nearby cells.

BACTERIOPHAGE Dr Vidya Pai Bacteriophage Phage Definition Viruses

BACTERIOPHAGE Dr Vidya Pai

Bacteriophage (Phage) � Definition - Viruses that infect and multiply inside bacteria by making use of some or all of the host biosynthetic machinery � Significance ◦ Models for animal cell viruses ◦ Gene transfer in bacteria ◦ Medical applications �Identification of bacteria - phage typing �Treatment and prophylaxsis? ? ?

Figure Bacteriophage

Composition and Structure � Composition ◦ Nucleic acid Head/Capsi d �Genome size �Modified bases ◦ Protein �Protection �Infection • Structure (T 4) – Size – Head or capsid – Tail Contractil e Sheath Tail Fibers Tail Base Plate

Each phage attaches to a specific cell surface molecule (usually a protein) and so only cells bearing that “receptor” can be infected by a given phage.

Two Basic Types 1. Lytic phage: eg. T phage infect a bacterial cell DNA replication coat proteins expression host cell lysed to release the new phage

The lytic growth cycle Figure 21 -1

2. Temperate phage: eg. Phage λ �Lysogeny —the phage genome integrated into the bacterial genome and replicated passively as part of the host chromosome, coat protein genes not expressed. • The phage is called a prophage. • Daughter cells are lysogens.

Figure 21 -2 The lysogenic cycle of a bacteriophage

�The lysogenic state can switch to lytic growth, called induction. Excision of the prophage DNA replication Coat proteins expression Lytic growth

Figure 16 -24 Growth and induction of λ lysogen

Assays of Phage Growth Bacteriophage Ø Progagate phage: by growth on a suitable bacterial host in liquid culture. Ø Quantify phage: plaque assay

Progagate phage ØFind a suitable host cell that supports the growth of the virus. ØThe mixture of viruses and bacteria are filtered through a bacterial-proof filter.

Quantify phage ØPhage are mixed with and adsorb to bacterial cells. ØDilute the mix. ØAdd dilutions to “soft agar” (contain many uninfected bacterial cells). ØPoured onto a hard agar base. ØIncubated to allow bacterial growth and phage infection.

Soft agar Hard agar a petri dish

Assay for Lytic Phage • Plaque assay – Method – Plaque forming unit (pfu) – Measures infectious particles Bacteria + Phage
As the viruses replicate and are released, they spread and infect the nearby cells. This circle-of-death produces a hole or PLAQUE in a lawn of living cells. These plaques can be easily seen and counted so that the numbers of virus can be quantitated.

The Single-Step Growth Curve Bacteriophage Latent periodthe time lapse between infection and release of progeny. Burst size-the number of phage released Figure 21 -4

The Single-Step Growth Curve ØIt reveals the life cycle of a typical lytic phage. ØIt reveals the length of time it takes a phage to undergo one round of lytic growth, and also the number of progeny phage produced per infected cell.

Medical Applications of Phage � “I strongly believe phage could become an effective antibacterial tool” - Carl Merril, Chief of the Laboratory of Biochemical Genetics, National Institute of Mental Health, NIH. � “It might be another string on the bow, such that when (conventional antibiotics) fail, here’s something that has a chance of working. But it’s not going to be a panacea” - Joshua Lederberg, Sackler Foundation Scholar at The Rockefeller University Reassessment of Medicinal Phage Spurs Companies to Study Therapeutic Uses American Society for Microbiology News 64: 620 -623, 1998

Significance of Lysogeny � Model for animal virus transformation � Lysogenic or phage conversion A change in the phenotype of a bacterial cell as a consequence of lysogeny �Modification of Salmonella O antigen �Toxin production by Corynebacterium diphtheriae
- Slides: 21